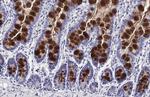
MUC2 Antibody in Immunohistochemistry (Paraffin) (IHC (P))

Search
Invitrogen
MUC2 Recombinant Rabbit Monoclonal Antibody (HL1724)
{{$productOrderCtrl.translations['antibody.pdp.commerceCard.promotion.promotions']}}
{{$productOrderCtrl.translations['antibody.pdp.commerceCard.promotion.viewpromo']}}
{{$productOrderCtrl.translations['antibody.pdp.commerceCard.promotion.promocode']}}: {{promo.promoCode}} {{promo.promoTitle}} {{promo.promoDescription}}. {{$productOrderCtrl.translations['antibody.pdp.commerceCard.promotion.learnmore']}}
产品信息
MA5-47157
种属反应
宿主/亚型
Expression System
分类
类型
克隆号
抗原
偶联物
形式
浓度
规格
纯化类型
保存液
内含物
保存条件
运输条件
RRID
产品详细信息
Store as concentrated solution.
Centrifuge briefly prior to opening vial.
靶标信息
Secreted epithelial mucins are large macromolecules which exhibit extreme polydispersity. Mucin 2 is the major intestinal mucin. O-glycans are attached to MUC2 in a potentially diverse arrangement, which is crucial for their interaction with endogeneous and exogeneous lectins.
仅用于科研。不用于诊断过程。未经明确授权不得转售。
篇参考文献 (0)
生物信息学
蛋白别名: colonic mucin; intestinal mucin; Intestinal mucin-2; MCM; MUC-2; MUC2; mucin 2, intestinal/tracheal; Mucin-2; mucin-like protein; secreted gel-forming mucin
基因别名: 2010015E03Rik; HH-Muc; MCM; MLP; MUC-2; MUC2; SMUC; wnn
UniProt ID: (Human) Q02817
Entrez Gene ID: (Human) 4583, (Rat) 24572, (Mouse) 17831